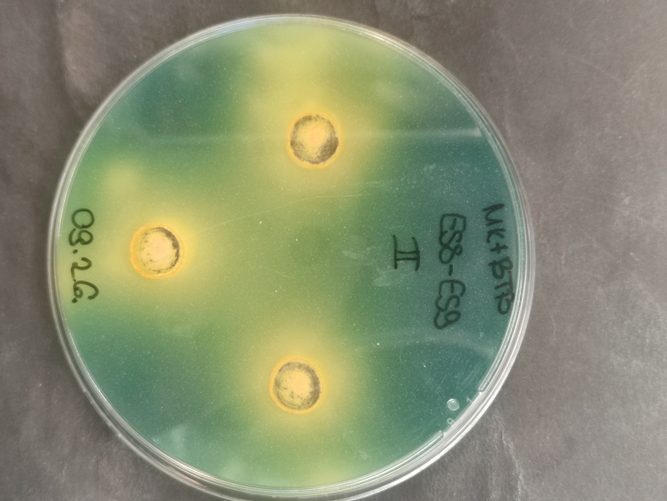
kísérlet káliummobilizáló képesség
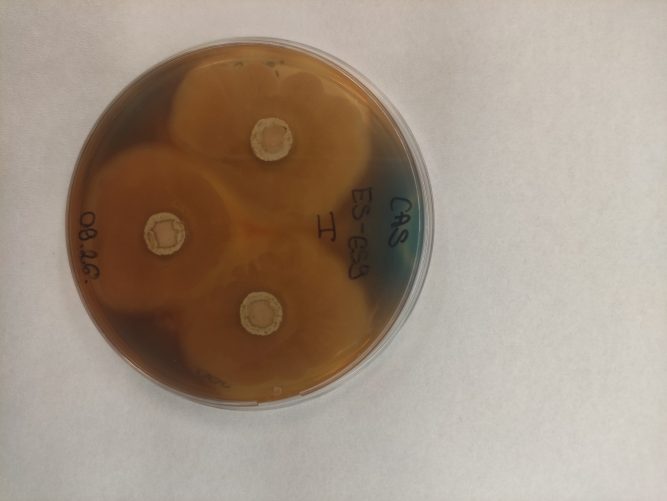
sziderofór-termelés laboratóriumi teszt eredmény

* az égető problémákra fókuszál:
* aszálytűrés, nitrogén-kötés, biokontroll-hatás
* 3 az 1-ben megoldást kínál, stabil, hosszan eltartható termék, alacsony dózissal
Az elmúlt években a gazdálkodók igen jelentős nehézségekkel szembesültek agrometeorológiai és ökonómiai tekintetben egyaránt. Az időjárási változások okozta tényezők indokolttá teszik a megszokott agronómiai gyakorlatok átgondolását. Minden apró hozzájárulás, ami a talajélet fejlesztését célozza, és lehetővé teszi a talaj szerkezetének, vízháztartásának és a növények stressztűrésének javítását elengedhetetlen a hatékony termeléshez.
Az elmúlt években a tápanyag utánpótlás költségei is jelentősen emelkedtek, valamint a patogének okozta fertőzések is egyre komolyabb toxinproblémákat okoznak. Figyelembe véve, hogy a fenti kockázatok várhatóan a következő években is velünk maradnak, érdemes komolyabb figyelmet fordítani arra az agronómiai potenciálra, ami talajaink biológiai erejében rejlik.
A Biofil Terra Kft. több éves kutatómunkával kifejlesztett új terméke a TerraGreen N mikrobiológiai készítmény éppen azon termelők számára készült, akik maximálisan ki szeretnék aknázni a talajaikban rejlő potenciált, ugyanakkor a talajt építeni és nem kizsarolni szeretnék, annak egyedülálló ökoszisztémáját is támogatni kívánják.
A TerraGreenN készítmény Bacillus és Azospirillum törzseket tartalmaz, amelyek speciális kombinációjának köszönhetően kiemelkedő módon képes a talajokat támogatni a következő funkciói segítségével:
1. Talajszerkezet javítása: a törzsek kiemelkedő EPS (exopoliszacharid) termelésének hatására talaj szerkezet javul, mikroaggregátumok képződnek. Ennek hatására a talaj sokkal több vizet képes elraktározni, nő a növényi aszálytűrés! A mikroaggregátumok képződésének hatására a talaj a hirtelen lezúduló csapadékok szerkezetromboló hatásának jobban ellenáll.
2. Nitrogénkötés: a készítményben található nitrogénkötő baktériumok a levegőben mindenhol és nagy mennyiségben jelen lévő, stabil nitrogén (N2) molekulákat bontják fel, majd nitrogén-fixációval a növények által felvehető ammónium-ionná (NH4) alakítják nitrogenáz enzim segítségével. A készítmény úgynevezett asszociatív nitrogénkötő baktériumokat tartalmaz, amelyek a gabonafélék gyökérkörnyezetében kifejezetten jellemzően megtalálhatóak, nem alakítanak ki szimbiotikus kapcsolatot, de a gyökér felületét és a gyökérszövet sejt közötti járatait képesek kolonizálni. Így közvetlenül a kultúrnövényt képesek annak igénye szerint nagy mennyiségű nitrogénnel ellátni.
3. Tápanyag mobilizálás: a készítményben található baktériumok képesek a talajban kötött formában jelen lévő, de a növények számára nem felvehető cink, kálium és vas mobilizálására (1. ábra). A cink kiemelten fontos tápanyag a kukorica esetében, de más növényi kultúrákban is meghatározó szerepe van a növekedés és fehérjeszintézis szabályozásában, és az aszálytűrés fokozásában! A kálium szintén kiemelten fontos elem, amely szabályozza a növényi vízháztartást, fokozza a növényi szárazság és stressztűrést! A vas a fotoszintézis szabályozásában, az enzimatikus folyamatokban és a növényi légzés szabályozásában elengedhetetlen.
4. Biokontroll hatás: a készítmény úgynevezett sziderofórok termelésével (2. ábra), kelátképzéssel megkötik a talajban található vas (Fe3+) ionokat, ezáltal a gombák és patogének számára vashiányos környezetet teremtenek. Az így megkötött vas a növények számára felvehető, és korlátozottá válik a talajlakó patogének (pl.: fuzáriumok) élettere.
A fentiekből jól látható, hogy a készítmény kifejezetten a jelen növénytermesztési problémáinak megfelelően került kifejlesztésre, és ezekre ad fenntartható módon, mikrobiológiai választ. Az EPS termelés révén javul a talaj szerkezete és a gyökérkörnyezetben kialakult biofilm hálózat élőhelyet biztosít a hasznos baktériumok számára. A nitrogénkötéssel és tápanyagok mobilizálásával növeli a növényi stressztűrést, az aszálytűrést fokozó tápelemekkel látja el a növényt, biokontroll hatása révén pedig maximalizálja a várható terméspotenciált.

A készítmény alkalmazásával a tudatos termékfejlesztésnek köszönhetően az engedélyeztetéshez szükséges kísérletekben is kiváló eredményeket sikerült elérni napraforgó (3. ábra) és kukorica (4. ábra) kultúrákban is, amelyek a fenti tényezők összképeként tükrözik, a termék igen hatékonyan képes ellátni feladatát. A termék 0,6-1 l/ha dózisban alkalmazható.

kultúrában a TerraGreenN készítmény különböző dózisaival, Baranya Vármegye: Szalánta, 2023
Mindkét kísérleti eredmény igazolja, hogy a TerraGreenN mikrobiológiai készítmény, konvencionális technológiába beiktatva is képes kiváló hozamfokozó hatást biztosítani, amellett, hogy alkalmazásával a talajéletet és szerkezetet is pozitív irányban befolyásoljuk.
További információkért keresse fel honlapunkat, vagy Facebook oldalunkat.

Agrárágazat Tudástár: Asszociatív nitrogénkötő mikrobiológiai készítmény – Olyan talajoltó készítmény, amely Bacillus és Azospirillum baktériumtörzsek segítségével a növény gyökérkörnyezetében jellemzően megtalálhatóak, nem alakítanak ki szimbiotikus kapcsolatot, de a gyökérfelületét és a gyökérszövet sejt közötti járatait képesek kolonizálni. Így közvetlenül a kultúrnövényt képesek annak igénye szerint nagy mennyiségű nitrogénnel ellátni.

